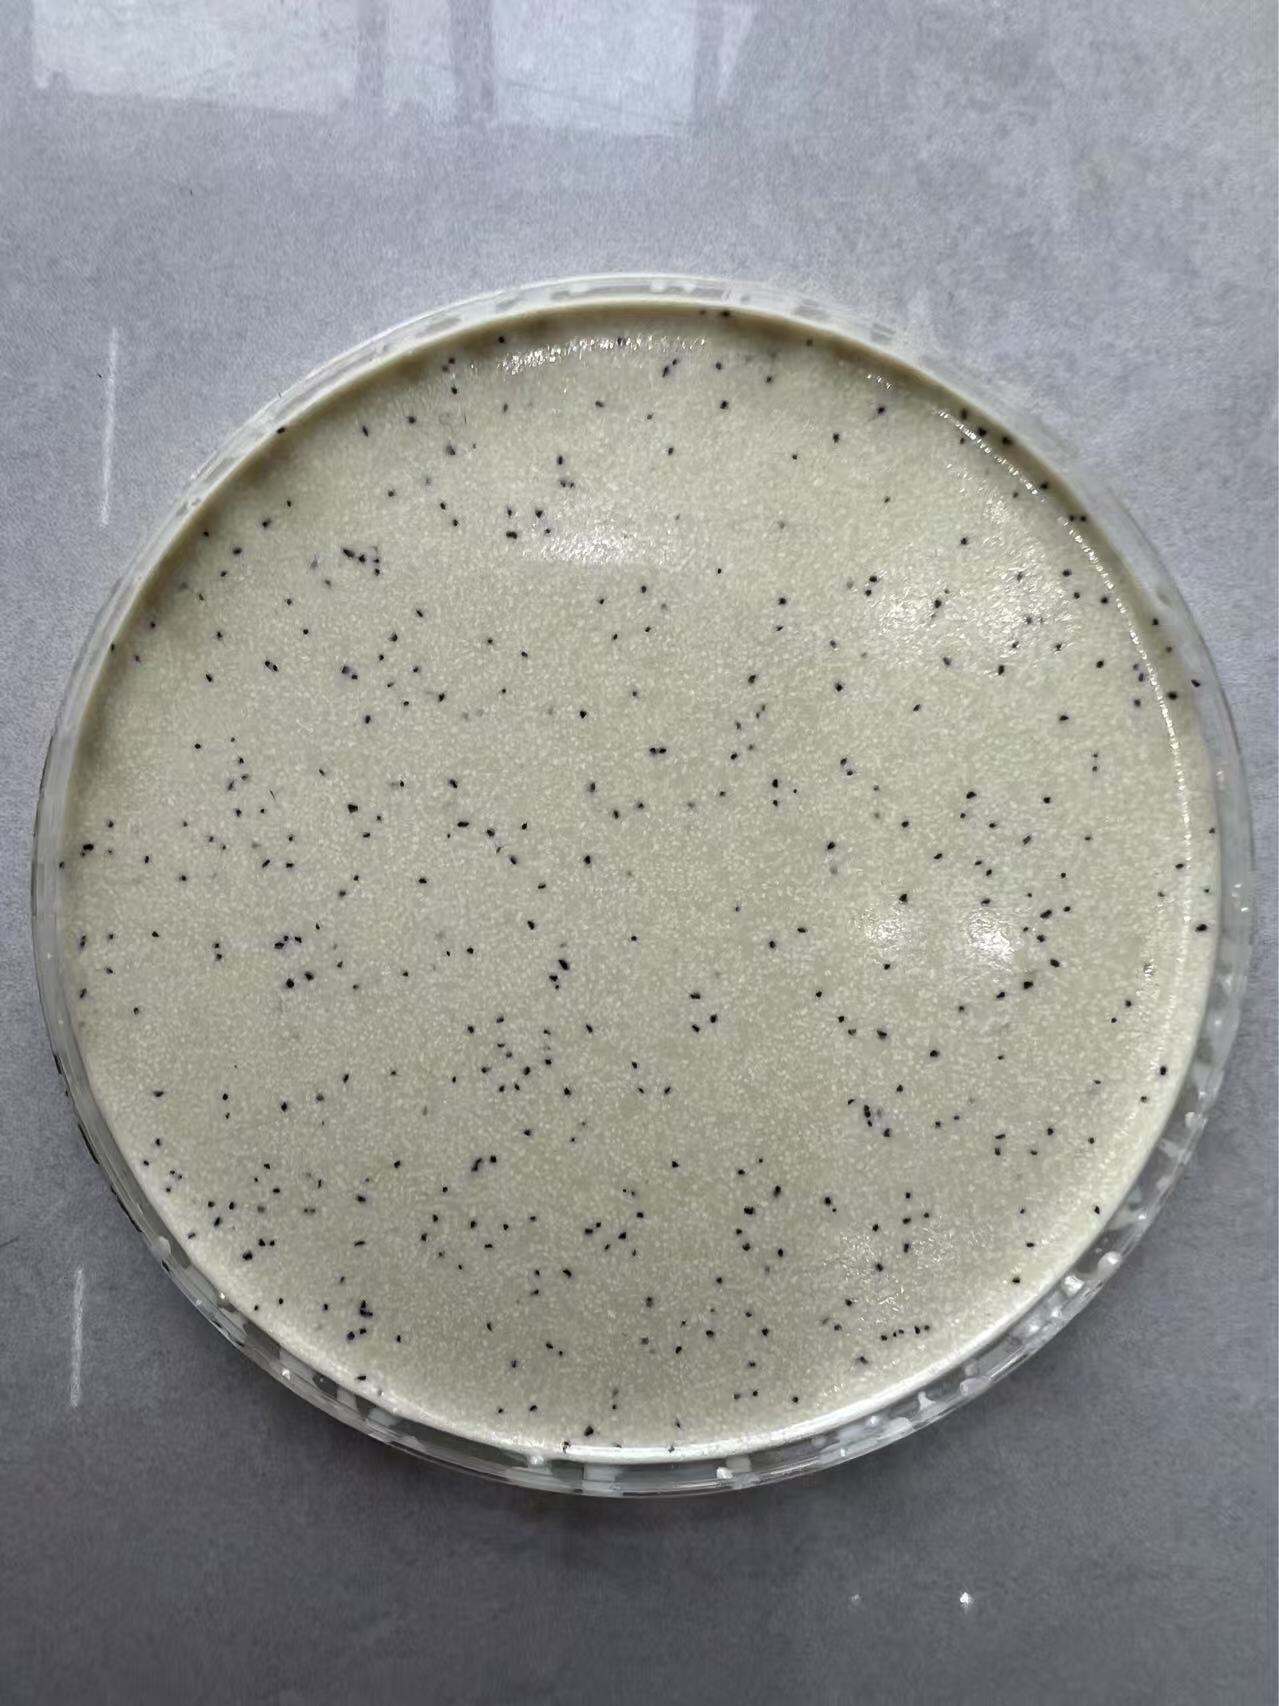
Preços por atacado econômicos e eficiência na instalação

venda por atacado de areia colorida epóxi
A venda por atacado de areia colorida epóxi representa um material revolucionário para pisos que combina durabilidade, estética e funcionalidade em uma solução abrangente. Este produto inovador é composto por resinas epóxi especialmente formuladas misturadas com partículas de areia colorida de alta qualidade, criando uma superfície contínua e atraente, adequada para diversas aplicações comerciais e residenciais. O sistema de areia colorida epóxi vendido por atacado oferece excelente resistência química, tornando-o ideal para ambientes expostos a produtos químicos agressivos, óleos e solventes. As principais funções da areia colorida epóxi vendida por atacado incluem proteção superficial, realce decorativo e manutenção da durabilidade a longo prazo. O material forma uma barreira não porosa que impede a penetração de umidade, ao mesmo tempo em que oferece superior resistência à abrasão causada por intenso tráfego pedonal e desgaste mecânico. As características tecnológicas da areia colorida epóxi vendida por atacado englobam uma avançada química polimérica que garante aderência ideal aos substratos de concreto, excelente estabilidade UV para evitar o desbotamento das cores e propriedades autorreguladoras que facilitam a aplicação uniforme. O componente de areia colorida proporciona variação de textura e resistência ao escorregamento, tornando as superfícies mais seguras para o tráfego pedonal. As aplicações da areia colorida epóxi vendida por atacado abrangem instalações industriais, espaços comerciais, instituições de saúde, edifícios educacionais, estabelecimentos varejistas e garagens residenciais. A versatilidade deste material torna-o adequado para áreas que exigem tanto apelo estético quanto desempenho funcional. As instalações fabris beneficiam-se das propriedades de resistência química, enquanto os espaços varejistas valorizam as possibilidades decorativas. O aspecto de venda por atacado garante aquisição economicamente vantajosa para projetos de grande escala, permitindo que empreiteiros e gestores de instalações obtenham resultados profissionais dentro das restrições orçamentárias. A instalação envolve a preparação adequada da superfície, a aplicação de primer, a instalação da demão de base epóxi, a espalhamento da areia colorida e, por fim, a aplicação de uma demão protetora superior. Essa abordagem sistemática garante desempenho e durabilidade ideais, tornando a areia colorida epóxi vendida por atacado um investimento que gera valor consistente ao longo de períodos prolongados.